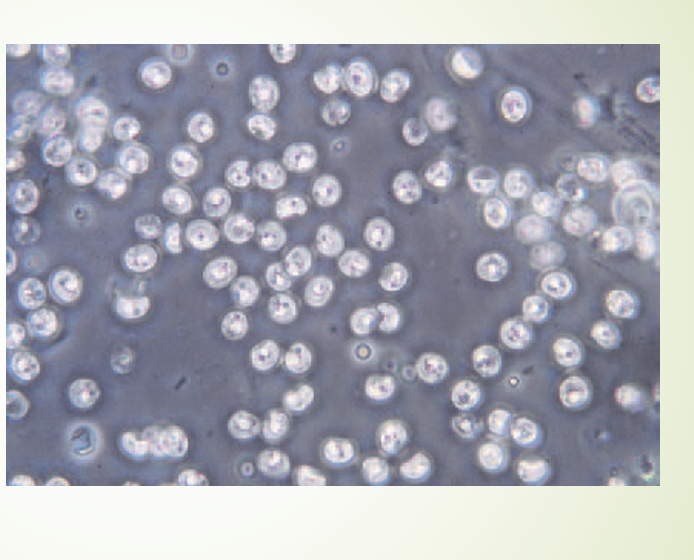
term image

Identification of parasites
0.0(0)
0.0(0)
Card Sorting
1/30
There's no tags or description
Looks like no tags are added yet.
Study Analytics
Name | Mastery | Learn | Test | Matching | Spaced |
|---|
No study sessions yet.
31 Terms
1
New cards

Flea
2
New cards

Larvae of a flea
3
New cards

Flea
4
New cards

Larvae of a flea
5
New cards

Lice
6
New cards

Lice
7
New cards

Sarcoptes scabiei
8
New cards

Demodex sp.
9
New cards

Demodex canis
10
New cards

Demodex cati
11
New cards

Demodex gatoi
12
New cards

cheylettiella
13
New cards

Cheyletiella
14
New cards

Otodected cynotis
15
New cards

Spinous ear tick
16
New cards

soft tick
17
New cards

Brown dog tick
18
New cards

Lone star tick
19
New cards

American dog tick
20
New cards

Deer tick
21
New cards

roundworms
22
New cards

Hookworms
23
New cards

Whip worms
24
New cards

Tapeworms
25
New cards

Taeniid tapeworm
26
New cards

Canine taeniid tapeworm
27
New cards

Giarrdia
28
New cards

Cystoisopora Causes cocciidiosis
29
New cards

Toxoplasma gondii
30
New cards
Cryptosporidium
31
New cards

Top and bottom
top= Dirofilaria Reconditum
bottom= Dirofilaria Immitus